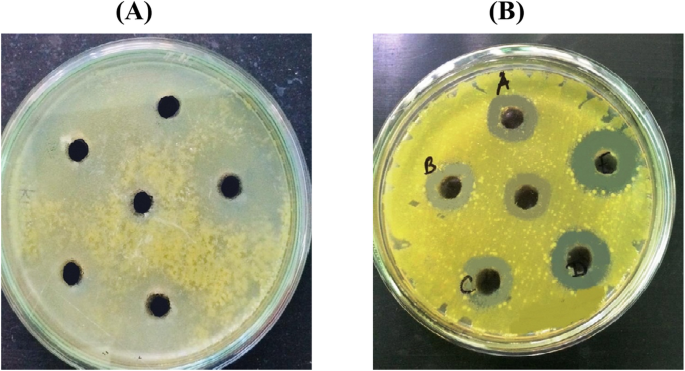

- Research
- Open access
- Published:
Potent bioactive methanolic extract of wild orange (Citrus macroptera Mont.) shows antioxidative, anti-inflammatory, and antimicrobial properties in in vitro, in vivo, and in silico studies
Bulletin of the National Research Centre volume 44, Article number: 81 (2020)
Abstract
Background
There is always an increasing demand for natural remedies from natural sources which can substitute the synthetic therapeutic drugs and lessen their side effects. The present study aims to investigate the antioxidant, anti-inflammatory, antimicrobial properties and in silico docking study of Citrus macroptera leaf (CML) extract in both in vivo and in vitro aspect.
Material and methods
The antioxidant and anti-inflammatory potential of crude extract was investigated in vitro and in vivo on Wistar albino rat. The antioxidant potentiality also investigated on HepG2 cell line. Antimicrobial activity was evaluated against Staphylococcus sp. and Klebsiella sp. Chemical compounds of the crude extract were identified by GC-MS analysis. In silico docking was also done against NF-ҡB protein.
Results
At 200 μg/ml concentration, CML significantly scavenges reactive oxygen species (ROS) which was generated on HepG2 cell line. CML showed 71% anti-inflammatory activity (p ≤ 0.001) against carrageenan-induced paw edema in albino Wistar rats. CML extract is very effective against staphylococcus sp. than Klebsiella sp. In the docking analysis, the proximadiol and menthone had − 5.6 kcal/mol and − 5.7 kcal/mol binding affinity with the protein NF-ҡB.
Conclusion
In the present work, CML provided notable antioxidant, anti-inflammatory, and antimicrobial activity. This activity was confirmed by both in vitro and in vivo followed by in silico docking technique. Overall, the experimental results presented in this study suggest that crude extract of CML could be used as a promising antioxidant and anti-inflammatory candidate with potential benefits.
Introduction
Oxygen (O2) is a significantly influential element for all aerobic organisms. There would be no existence of life without oxygen. However, at higher concentration, oxygen could be toxic to aerobes (Bulkley 1983). ROS, which contain oxygen, are chemically responsive molecules due to the presence of unpaired electrons and is the major cause of oxidative stress. Most of the vandalizing outcomes of oxygen is due to ROS, which include superoxide anion radicals (O2•−), hydroxyl radicals (OH•), and non-free radical species such as ozone (O3), hydrogen peroxide (H2O2), and singlet oxygen (1O2) (Balaydin et al. 2010). It is generally well established that free radicals play a significant role in the progression of tissue attrition which is related to serious cell damage leading to inflammatory events (Bursal et al. 2013).
ROS increases abnormally during inflammation causing an imbalance between the oxidizing molecule and the antioxidant system of the body (Stadtman 1992). The humoral and cellular mechanisms of inflammation are innumerable and very complex. They involve gene regulatory factors such as the NF-κB and signaling substances synthesized by immune cells such as cytokines and prostaglandins (Ahmed 2011). Inflammation is triggered by many stimuli like pathogens and antigen-antibody interaction (Osadebe and Okoye 2003). Besides, it is a protective response involving immune cells, blood vessels, and molecular mediators. Anti-inflammatory agents like non-steroidal anti-inflammatory drugs (NSAIDs), steroids, and immunosuppressants are often used for the repercussion of inflammation. But their use is often associated with serious side effects such as gastrointestinal bleeding and peptic ulcers (Corley et al. 2003). This has led to the search for alternative treatments (Cheung et al. 2007). In order to diminish the harmful effects of synthetic drugs, use of antioxidants directly procured from herbal products is very trustworthy because of their low side effects, low cost, and ready availability (Sheir et al. 2001).
Citrus macroptera Montr. is a semi-wild species of the family Rutaceae native to Malesia and Melanesia (Paul et al. 2015). It is alternatively known as Melanesian papeda, wild orange, hatkhora, and satkara (Hanelt 2001). In India, it is naturalized in the north-eastern part. There are reports regarding C. macroptera that the fruits exert anti-diabetic activity in experimental type 2 diabetic rats (Uddin et al. 2014). Moreover, C. macroptera fruit peel was shown to exhibit significant neuropharmacological effects against oxidative stress (Rahman et al. 2014).
However, no significant work has been done with C. macroptera leaf (CML) extract; especially so far, there is no report of antioxidant, anti-inflammatory, and antimicrobial properties of the extract. Therefore, in the present study, a detailed profiling of antioxidants has been done which is directly associated with oxidative stress-related diseases (Gross and Hen 2004). For further validation of in vitro results, we also checked the activity of CML in Wistar rat model (in vivo) followed by in silico docking for strong establishment of in vitro and in vivo results. Particular importance was also given to those bioactive chemical compounds which were identified in GC-MS analysis which might be responsible for its potent bioactivities.
Material and methods
Collection and identification of plant materials
The leaves were collected from the naturally growing plants from NBU Campus, Siliguri. The plant sample was identified by Plant Taxonomy and Biosystematics laboratory in the Department of Botany (Voucher specimen accession no-10333).
Drugs, chemicals, and reagents
Drugs, chemicals, and reagents used in the present study were of molecular biology and analytical grade and purchased from HiMedia Laboratories Pvt. Ltd., Mumbai, India; Merck, Mumbai, India or Thomas Baker, India. Diclofenac sodium was procured as Voveran-SR (Novartis India Ltd., Mumbai, India) and indomethacin (Jagsonpal Pharmaceutical Ltd., New Delhi, India) was purchased from drug suppliers.
Preparation of extract
Leaves were washed with tap water three times to remove the dirt. After soaking, they were crushed in grinder. Exhaustive extraction was performed in Soxhlet apparatus (plant material: solvent was 1:10 m/v) for 6–7 h using methanol as solvent. The extract was then concentrated under reduced vacuum pressure at 40 °C in a rotary vacuum evaporator (Buchi Rotavapor R-3, Switzerland). Obtained concentrated extract was then stored in − 20 °C for further use.
Ethical statement
All the experiments using animals were monitored, reviewed, and approved by the Animal Ethical Committee of Department of Zoology, NBU (Permit No. 840/ac/04/CPCSEA, Committee for the Purpose of Control and Supervision of Experiments on Animals).
Animal maintenance
Male Wistar albino rats were used for all the experiments. Animals were procured from authorized animal vendors of Kolkata, India. Adult rats (n = 5) were kept in polypropylene cages (Tarson, India), with paddy husk as bedding material. The experimental rats were maintained in the animal house of the Department of Zoology, University of North Bengal with sufficient food and water under a constant 12 h dark/light cycle at 24 ± 2 °C. The animals were acclimatized for at least 7 days prior to the initiation of the experiments.
In vitro antioxidant assays
Determination of hydrogen donating ability (DPPH assay)
The free radical scavenging activity through DPPH assay was performed following the method described by Saha et al. (2016) with minor modifications in extract concentration. Different concentrations (50–200 μg/ml) of the plant extract were prepared and mixed properly with freshly prepared DPPH solution (1 mM, diluted in 95% methanol) and kept in dark. Optical density (OD) was measured at 517 nm using Bio-Rad micro plate reader and compared with the standard ascorbic acid. The percent of inhibition was calculated using the following Eq. (1):
where A0 = absorbance of the control and A1 = absorbance in the presence of samples and standard.
And the IC50, i.e., half maximal inhibitory concentration values were calculated by the formula:
where A1 = IC50, Y = response (Y = 100% when X = 0), X = inhibitory concentration.
Determination of reducing power
The Ferric reducing power assay was evaluated by the method of Saha et al. (2016) with slight alterations in extract doses. Different concentrations (50–200 μg/ml) of the plant extract (500 μl) were mixed with 0.2 M of phosphate buffer (pH 6.6) and 0.1% of potassium hexacyanoferrate, followed by incubation at 50 °C for 30 min in a water bath. After incubation, 500 μl of TCA (10%) was added to the mixture to stop the reaction. The upper aqueous portion of the reaction mixture was then transferred to another tube and mixed with 1 ml of distilled water followed by 0.01% of FeCl3 solution. The mixture was left for 15 min at room temperature and the absorbance was measured at 700 nm. Butylated hydroxytoluene (BHT) was used as standard.
Metal chelating activity
The chelating activity of ferrous ion by methanolic CML extract was determined by Saha et al. (2016) with slight alterations in extract doses. Various concentrations of CML extract (50–200 μg/ml) were mixed properly with ferrous sulfate (FeSO4) solutions (12.5 μM) in HEPES buffer (pH 7.2) accompanied by the addition of ferrozine (75 μM) to initiate reaction. The reaction mixture was trembled vigorously and incubated for 30 min at room temperature. The formed ferrous ion-ferrozine complex was measured at 562 nm. EDTA was used as positive control.
Hydroxyl radical scavenging assay
Hydroxyl radicals generated on the basis of Fenton reaction (Fe3 + -ascorbate-EDTA-H2O2 system) were determined with little modifications in extract concentrations. A reaction mixture was prepared containing 2-D-ribose (3 mM), monopotassium phosphate-potassium hydroxide buffer (KH2PO4-KOH, 25 mM, pH 7.4), ferric chloride (FeCl3, 100 μM), EDTA (100 μM), H2O2 (1.0 mM), ascorbic acid (100 μM), and various concentrations of extracts (0–200 μg/ml) up to a final volume of 2 ml and the reaction mixture was left for 1 h incubation at 37 °C. Following incubation, 1 ml of incubated mixture was taken into another tube and mixed with 1 ml of TCA (2.8%) and 1 ml of aqueous TBA (1%). The final mixture was incubated at 90 °C for 20 min then cooled down to room temperature. The absorbance was measured at 532 nm against a blank solution. Mannitol was used as positive control. Hydroxyl radical scavenging activity was measured by aforesaid Eq. (1).
NO radical scavenging activity
NO radical scavenging assay was done by the procedure described by Saha et al. (2016) with changes in the extract concentrations. In brief, phosphate buffered saline (pH 7.4), sodium nitroprusside (10 mM), and various concentrations of CML (50–200 μg/ml) were mixed to make final volume of 4 ml. After incubation for 1.5 h at 25 °C, 0.33% of sulfanilamide (diluted in 20% of glacial acetic acid) was added to 0.5 ml of the pre-incubated reaction mixture and left for 5 min. Following the incubation, 1 ml of N-(1-naphthyl)ethylenediamine dihydrochloride (NED, 0.1%) was added and incubated for 30 min at 25 °C to develop the color. The percentage inhibition was calculated using Eq. (1). The absorbance was measured at 540 nm. Curcumin was used as positive control.
Quantification of total phenol and flavonoid content
Determination of total phenol content was determined by Folin-Ciocalteu method (Singleton and Rossi 1965). In short, CML extract (100 μl) was mixed with Folin-Ciocalteu reagent (previously diluted 1000-fold with distilled water) and left for 5 min at room temperature followed by the addition of sodium carbonate (0.06%) to the mixture. After incubation of 90 min at room temperature, the absorbance was measured at 740 nm. The phenolic content was measured against a gallic acid standard curve (R2 = 0.986, y = 0.007 × − 0.025).
Total flavonoid content was determined according to aluminum chloride (AlCl3) method (Zhishen et al. 1999) with slight modifications. CML extract (100 μl) was added to 0.3 ml of distilled water followed by addition of 5% sodium nitrate (NaNo2). After 6 min of incubation at room temperature, 10% AlCl3 was added and left for 5 min. The reaction mixture was then treated with 1 mM of sodium hydroxide and lastly diluted with distilled water. Absorbance was recorded at 510 nm. Data were reported as means ± SD for 3 replications. The flavonoid content was measured against quercetin standard curve (R2 = 0.962, y = 0.207 × − 0.204).
In vitro test of inflammation
Collection of blood sample and preparation of erythrocyte suspension
Erythrocyte suspension was prepared according to Modak et al. (2017). Briefly, fresh whole blood (3 ml) was collected from a healthy volunteer in an EDTA tube and was centrifuged (Sigma 3 K30) at 3000 rpm for 10 min. The pellet was collected and the equivalent volume of normal saline (0.9%) was mixed and then centrifuged to wash the RBC pellets thrice. Finally, the volume of the red blood pellets was measured and reconstituted as a 40% (v/v) suspension with isotonic buffer solution (pH 7.4) to obtain the stock erythrocyte or hRBC suspension.
hRBC membrane stabilizing activity
Hypotonic solution-induced hemolysis
The effect of the CML on hRBC hemolysis induced by hypotonic solution was assessed by the method of Shinde et al. (1999) and Modak et al. (2017). The dose values of extracts were modified according to our experimental designs. The experiments were carried out in triplicates for each experimental dose. First set of centrifuge tubes contained CML at a concentration of 250, 500, 750, and 1000 μg/ml in 5 ml of hypotonic solution (distilled water), and in another set of centrifuge tubes, similar graded doses of the CML were prepared in isotonic buffer solution (5 ml). In standard group, indomethacin (200 μg/ml) was used as a standard drug. One hundred microliters of stock erythrocyte suspension was then added to each of the centrifuge tubes and after gentle mixing, the mixtures were incubated for 1 h at 37 °C temperature. After incubation, the mixture was centrifuged for 3 min at 1300g in room temperature and the absorbance (OD) of the supernatant was measured at 540 nm using double beam UV-VIS spectrophotometer (Ray-Leigh UV-2601). The percentage of hemolysis was calculated by assuming the hemolysis produced in the presence of distilled water (hypotonic solution) to be 100%. Thus the percent inhibition of hemolysis was calculated using the following equation.
where absorbance of test sample in isotonic solution (OD1), hypotonic solution (OD2), and absorbance of control sample in hypotonic solution (OD3).
Heat-induced hemolysis
This test was carried out with the standard protocol described by Shinde et al. (1999) and Modak et al. (2017). Briefly for this test, control, experimental CML treated groups and one standard drug group were considered. The centrifuged tubes were arranged in triplicates per dose. First set, designated as control tubes contained only 5 ml of the distilled water (vehicle). In experimental groups, CML was dissolved in 5 ml of isotonic phosphate buffer solution (pH 7.4) at a concentration of 250, 500, 750, and 1000 μg/ml. The standard drug dose group contained 5 ml isotonic buffer solution containing indomethacin at a concentration of 200 μg/ml. An amount of 100 μl of erythrocyte suspension was added to each tube and mixed gently. The tubes were incubated at 54 °C for 20 min in a regulated water bath. After incubation period, the reaction mixture was centrifuged at 1300g for 3 min in room temperature and the absorbance (OD) of the supernatant was measured at 540 nm. The percent inhibition of hemolysis by the CML was calculated using the following equation.
where absorbance of heated test sample (OD1) and heated control sample (OD2)
In vivo test of inflammation
Acute toxicity test
Acute toxicity test were performed according to the OECD guideline 423 for acute oral toxicity study in rodents. The mortality rate, salivation, food and water intake, fur irritation, lethargy, and loss of body weight were observed for 24 h after the treatment. The rats were kept under observed for up to 7 days for any late sign of toxicological effects.
Carrageenan-induced paw edema in rat
The anti-inflammatory activity of CML was evaluated using carrageenan-induced paw edema restoration experiment in rats, described by (Gupta et al. 2006) with modifications in dose value of extracts. A total 25 numbers of Wistar albino rats were randomly divided into 5 groups each having five animals. The group 1 (vehicle group) indicated normal animals; group 2 indicated negative control group where paw edema was induced; groups 3 and 4 (low and high-dose groups respectively) were treated with 250 mg/kg b.w. and 500 mg/kg b.w. dose of CML treated orally once on a day after the paw edema was induced; and group 5 indicated standard drug group where paw edema was induced and standard diclofenac sodium (10 mg/kg of b.w.) (Gupta et al. 2015) was fed as an anti-inflammatory drug.
On the experimental day, following the pre-treatment with CML (1 h before) and 0.9% carrageenan injection (0 h), the swelling of the paw was recorded by measuring the paw circumference (in mm) using a vernier calliper immediately before pre-injection and at selected intervals at 0.083 (5 min), 1.083 (1 h 5 min), 2.083 (2 h 5 min), 3.083 (3 h 5 min), 4.083 (4 h 5 min), and 5.083 (5 h 5 min) hours after the carrageenan injection. Percentage of inhibition was calculated using following formula:
Where (Ct − C0) Negative control is the difference in the paw circumference in 5.08 h in negative control rats and (Ct − C0) Treatment is the difference in the size of paw circumference at 5.08 h in rat either treated with CML or standard drug.
Detection of intracellular ROS generation
H2DCFDA is used for the detection of hydrogen peroxide production in normal cells. Standard protocol (Wu and Yotnda 2011) was followed with slight modification for measurement of intracellular ROS. The oxidation of 2,7-dichlorofluorescein (H2DCF) to 2,7-dichlorodihydrofluorescein (H2DCFDA) was used for the determination of hydrogen peroxide (H2O2). Human liver cells (HepG2) were selected for the study and grown on cover slip in 35 mm Petri dishes and incubated for 24 h with 5% CO2 in N-biotech incubator. After 24 h incubation, HepG2 cells were treated with the highest experimental concentration of CML extract (dissolved in DMSO at 200 mg/mL). Control plate was kept without treatment with the CML extract. Cells were incubated for 24 h at the same conditions as given above and washed twice with phosphate buffer saline (PBS). Fresh serum media was added with 25 mM 2,7-dichlorofluoresceindiacetate and incubated for 30 min in the CO2 incubator. Immediately after incubation, HepG2 cells were washed thrice with serum free media and glass slides were prepared by inverting cover slips on the slide in 20% glycerine/PBS solution. Cells were observed under LED-based fluorescence microscope (Magnus MLXi) and excited at 480 nm using LED cassettes and emission was collected using a long pass filter. The cells were observed at × 10 magnification and images were captured by digital SLR Olympus camera mounted on the head for high-resolution image.
Microbiological screening
Antimicrobial activity of methanolic CML extract was evaluated by the agar well diffusion method which was modified by Olurinola (1996), and minimum inhibitory concentration (MIC) was determined by Akinyemi et al. (2005).
Culture and maintenance of microorganism
One gram positive (Staphylococcus sp.) and one gram-negative (Klebsiella sp.) bacteria were used in this experiment. The pure cultures of bacterial were maintained on nutrient agar [40 g/L] medium. Each bacterial culture was further maintained by subculturing regularly on the same medium, incubated at 37 °C for 24 h and finally stored at 4 °C before use in this experiment.
Screening for antibacterial activity
For agar well diffusion method, antimicrobial susceptibility was tested using media prepared with agar (20 g/1 L) and MH broth (21 g/1 L) in 1 L conical flask. The media prepared was then sterilized by autoclaving at 120 °C for 20 min.
Petri plates were prepared by pouring 25 ml of media. Petri plates were allowed to stand for 30 min for solidifying the media completely. Freshly prepared bacterial inoculums [diluted 1:1 with sterile water] was then evenly spread using a sterile cotton swab upon the entire agar surface. A 6 mm hole was then punched with a sterile cork borer and a 100 μl volume of each plant extract with a concentration of 10 mg/ml was pipetted into triplicate wells. The plates were incubated at 37 °C for 24–48 h and the inhibition zone diameter was taken in three different fixed directions and the average value was recorded. DMSO (dimethyl sulfoxide) served as control.
Determination of the MIC
One hundred microliters of extract with different concentrations [0.5ul/ml–10 mg/ml] was poured into the well. Petri plates were incubated overnight at 37 °C. Parallelly controls were run in which the solvent [DMSO] of the plant extract was dissolved. The plates were observed for inhibition zones after 24 h and the readings were measured in three different fixed directions and the average values were recorded accordingly.
The antimicrobial activity of selected compounds obtained from GCMS analysis was considered for docking analysis. The FtsZ protein of Staphylococcus aureus was taken as our target. FtsZ is a very special protein involved in cell division and is one of the major house-keeping genes of microbes (Guan et al. 2018). The pdb format of this protein (PDB id 3VOB) was downloaded from RSCB PDB databank. In silico docking analysis was done through the Autodock vina software.
GC-MS analysis
The bioactive compounds of CML extract were identified by GC-MS analysis according to standard methods with slight modifications (Dey et al. 2015). Thermo Scientific Trace 1300 GC, equipped with ISQ-QD (Thermo Scientific) single quadruple mass analyzer and TG-5MS column (30 m 3 0.25 mm 3 0.25 lm) were employed for the identification of bioactive compounds. ThermoXcaliburTM software version 2.2 was used to analyze all the samples. Automated Mass Spectral Deconvolution and Identification System (AMDIS) version 2.70 was applied for the interpretation of MS data.
In silico docking
Carrageenan is well known for inducing the inflammatory response in animal models and human through activation of NF-κB with increased IL-8 production (Borthakur et al. 2012). Hence, we selected a structure of the nuclear factor kappa-b (nf-kb) p50 homodimer from Rattus rattus for our docking study. The X-ray diffraction structure of this protein (PDB id INFK) was obtained from PDB database (https://www.rcsb.org/structure/1nfk). The resolution of this structure was 2.3 Å which is good enough for docking study. CASTp server (http://sts.bioe.uic.edu/castp/) was used for active site and pocket prediction. The protein was finally prepared for docking after removing the water molecules and adding polar hydrogens. Relevant phytochemicals obtained and identified from the GC-MS analysis were used as ligands. Structures of those ligand molecules were downloaded from in sdf format NCBI PubChem database. Those structures were converted to PDB format through SMILES server. Autodock Tool 1.5.6 software was used for grid-based docking and results were visualized through PyMol version 1.7.4.
Statistical analysis
All qualitative data have been reported as the mean ± SD of three measurements. Animal based experiments are expressed as mean ± SEM. Statistical analysis and representation of statistical data were done using KyPlot version 5.0 (32 bit) and Graph Pad Prism version 7.00 for Windows (Graph pad Software Inc., San Diego, USA) using the one-way analysis of variance (ANOVA) followed by Dunnett’s multiple comparison test, where p < 0.001 was considered as significant.
Results
Determination of hydrogen donating ability (DPPH assay)
In the present antioxidant profiling, CML extract exhibited higher free radical scavenging activity (70.35 ± 1.6 at 200 μg/ml) than the respective standard (ascorbic acid) that showed a value 65.66 ± 1.3 at same concentration (Fig. 1a). This was evident from the development of yellow coloration after adding DPPH. The IC50 value of the extract was found to be much lower, i.e., 58.47 ± 2.27 μg/ml.
Antioxidant and free radical scavenging activity of CML extract. a DPPH radical scavenging activity (% of inhibition = 70.35 ± 1.6 at 200 μg/ml, IC50 = 58.47 ± 2.27 μg/ml); b hydroxyl radical scavenging activity (% of inhibition = 55.68 ± 0.5 at 200 μg/ml, IC50 = 91.14 ± 1.1 μg/ml); © Nitric oxide reducing activity (% of inhibition = 63.96 ± 1.8 at 200 μg/ml, IC50 = 70.87 ± 0.87 μg/ml); where α = p < 0.05 Β = p < 0.01, γ = p < 0.001, δ = non-significant when compared to standard
Hydroxyl radical scavenging assay
CML significantly scavenge hydroxyl radical in a concentration dependent manner, i.e., at highest concentration (200 μg/ml) OH. radical scavenging percentage was 55.68 ± 0.5 as compared to its standard Mannitol (Fig. 1b) with IC50 value 91.14 ± 1.1 μg/ml.
NO radical scavenging assay
At 200 mg/ml concentration, percentage of inhibition of CML is moderately significant activity (63.96 ± 1.8) compared with standard curcumin (Fig. 1c). The IC50 value of CML extract was 70.87 ± 0.8 μg/ml.
Iron chelating assay
In the present study, CML was found to fade the color of ferrozine-Fe2+complex, indicating its iron chelating activity due to presence of certain components. Moreover, the chelating percentage was found to 51.66 ± 0.5 at 1000 μg/ml (Fig. 2a).
Measurement of reducing power
The reducing power of CML extract was found to be increased in a dose dependent manner comparable to the reference compound BHT (Fig. 2b).
Determination of total phenolic and flavonoid Content
In this present study, the values of phenol and flavonoid were expressed as milligrams of gallic acid and quercetin equivalent per 1 g of CML. Total amount of phenol and flavonoid content of CML extract was 24.55 ± 2.5 mg and 10.76 ± 0.09 mg respectively.
In vitro test of inflammation
Membrane stabilizing activity
The experimental groups treated with CML extract showed excellent activity in membrane stabilization with a high significance for the heat-induced hemolysis test (7.73 ± 1.67, 11.09 ± 1.36, 14.15 ± 0.58, and 15.36 ± 0.89 respectively for 250, 500, 750, and 1000 μg/ml groups) (Fig. 3a). In the hypotonicity-induced hemolysis assay (Fig. 3b), the low-dose group (250 μg/ml) showed 4.55 ± 0.90% inhibition at a non-significant level. The higher-dose groups showed significant membrane lysis inhibition activity (9.96 ± 0.97, 12.63 ± 0.71, and 15.40 ± 1.9 respectively for 500, 750, and 1000 μg/ml groups). However, the inhibition of membrane lysis was highest in the standard indomethacin-treated groups (200 μg/ml).
In vivo test of inflammation
Acute toxicity test
The CML extract up to the dose of 2 g/kg body weight, showed no observable toxicological symptoms when fed for a single time.
Carrageenan-induced paw edema test
The low-dose group and high-dose groups (250 and 500 μg/kg b.w) showed a significant 39.94% and 71.07% (Fig. 4) of reduction in paw circumference respectively compared to untreated animals. The standard group, however, showed 83.03% reduction of paw swelling at a dose of 10 μg/kg b.w. (Table 1).
Measurement of ROS generation in HepG2 cell line
Human liver carcinoma cell line HepG2 was used to examine the effects of CML under oxidative stress. H2O2 increases oxidative stress levels in the liver tissue. Therefore, HepG2 cells were treated with H2O2 for 0 ± 24 h, and intracellular oxidative levels were measured using the dichlorofluorescein assay. Figure 5 a showed the control cells. Figure 5 b demonstrated that cells exposed to H2O2 exhibited significantly increase in ROS levels. Tremendous decrease in fluorescence was detected at higher doses of CML (200 μg/ml) compared to the H2O2 (Fig. 5c).
Effects of CML in depletion of intracellular ROS production generated by H2O2 in HepG2 cells. Production of ROS was measured by cleavage of acetate group of non-fluorescent H2DCFDA (2′,7′-dichlorodihydrofluorescein diacetate) which convert into DCF(2′,7′-dichlorofluorescein) highly fluorescent. Cells were exposed to H2O2 before treatment with CML at 200 μg/ml for 24 h. The ROS production displays the intensity of fluorescence through the images of HepG2 cells treated with different concentrations of CML: a control, b H2O2, and c CML extract
Microbiological screening
Quantification of antimicrobial activity using agar well diffusion method
The antimicrobial potential of CML extract was evaluated according to their zone of inhibition. At concentration 10 mg/ml, CML showed inhibition zone 20 ± 0.95 mm against Staphylococcus sp. and 11 ± 1.3 mm against Klebsiella sp. (Fig. 6). The antimicrobial activity was further established by molecular docking mechanism. We got the best docking result with copaene (Fig. 7), where the binding energy was − 6.2 kcal/mol (Table 2).
Determination of MIC value using agar well diffusion method
MIC value varied from 0.5 mg/ml to 2 mg/ml concentration. Among the five concentrations studied here, CML extract showed MIC 0.5 mg/ml in case of Staphylococcus sp. and 2 mg/ml in case of Klebsiella sp.
GC-MS analysis
Total 42 compounds were detected in GC-MS analysis. GC-MS results have depicted in Table 3.
Molecular docking envisages the cross talk between NF-κB and selected ligands
Menthone and proximadiol showed best binding affinities to 1NF-κB (Fig. 8). The binding energies were − 5.7 and − 5.6 kcal/mol (Table 4).
Discussion
The demand of antioxidants from natural origin has increased many folds because of their potential property to prevent and reduce the risk of several oxidative damage with minimal side effects (Aruoma 2003). In the present antioxidant profiling, CML leaf extract showed potential free radical scavenging activities. DPPH is a free radical that can accept an electron or hydrogen radical to become stable and reacts with reducing agent changing the color of the solution into pale yellow. Thus, DPPH scavenging activity by CML extract proves the presence of significant antioxidant properties. Human beings are exposed to H2O2 directly or indirectly via environment. This may produce hydroxyl radicals (OH.) that can cause lipid peroxidation and DNA damage in the body (Huang et al. 2005). Therefore, the ability of CML extract to scavenge H2O2 proves beneficial for our health. Nitric oxide has an important role as pro-inflammatory mediators. During chronic inflammation iNOS (calcium-independent isoform of NOS) is activated by lipopolysaccharide and produces huge amount of nitric oxide. The active NO. translocates NF-κβ and leads to the formation of chronic inflammation (Misko et al. 2013). In the present study, it is described that nitric oxide is downregulated by CML extract. Thus, CML might inhibit the inflammation related disorders. Free iron is a potential enhancer of ROS formation as it leads to reduction of hydrogen peroxide and generation of the highly aggressive OH−. In the present study, CML fades the color of ferrozine complex, indicating its iron chelating activity due to presence of certain components. However, the reducing power assay was found to be lower when compared to the standard BHT. The phenolic compounds having redox potential show a significant role in neutralizing the free radicals, scavenging singlet, and triplet oxygen. Similarly, flavonoids have also been reported to exert its antioxidant activity, as they act on enzymes and pathways involved in anti-inflammatory processes (Mustafa et al. 2010).
The in vitro anti-inflammatory assessment provides a baseline understanding of the efficacy of a drug or traditional drug in the regulation of lysosomal membrane stabilization. Lysosomal vesicular fluid contains different enzymes and is inflammation inducer. Thus, a stabilized membrane provides a protection against inflammatory proceedings. Erythrocyte membranes are proved model system for the study of stabilization of lysosomal membranes due to their structural similarity (Anosike and Obidoa 2012). In our experiments, the experimental groups treated with CML extract showed excellent activity in membrane stabilization for both the heat-induced and hypotonicity-induced hemolysis assay. However, the inhibition of membrane lysis was highest in the standard indomethacin-treated groups (200 μg/ml). The carrageenan induces an inflammatory condition in the rodent paw and the histamines, serotonins, and prostaglandins play key roles in the progression of the process (Gupta et al. 2006). The experiment indicates that the oral administration of CML is efficient in the inhibition of inflammation in carrageenan-injected animals with a high percentage (71%). The result indicates that the CML is a potent anti-inflammatory agent when used in the in vivo systems. The synergistic effect of the different bioactive compounds present in the CML extract could have a vital role in this regard.
Hydrogen peroxide (H2O2) is a stable free radical having important role in signaling pathways (Wu and Yotnda 2011). Oxidative stress is associated with increased levels of ROS productions in living cell. H2DCF-DA was used to distinguish the production of intracellular ROS generation. H2DCF-DA recognized hydrogen peroxide by exhibiting fluorescence on HepG2 cell line exposed to H2O2, as it induced oxidative stress. However, a considerable reduction in fluorescence intensity was seen with CML-treated group. This suggests that under the impact of CML, H2O2-induced ROS was reduced proportionately. From this experiment, it might be figured that CML plays an important role in reducing the impact of H2O2 on normal intracellular function.
In the antimicrobial assay, based upon inhibition zone, it is clearly shown that the CML extract is very effective against gram positive than the gram-negative bacteria with a lower MIC value.
Several compounds with potential therapeutic significance have been detected with the help of GC-MS analysis. Several phytochemicals belonging to long chain fatty moiety and their derivatives such as hexadecanoic acid, octadecadienoic acid, and phytol have been identified in the samples. Interestingly, these long chain fatty acids play an important role in plant development. Out of 42 compounds found in CML, neophytadiene has anti-cancerous and anti-proliferative activity (Arora and Kumar 2018). Proximadiol has been used as antispasmodic drug (Evans et al. 1982). Stigmasterol which is a good antioxidant compound also shows hypoglycemic and thyroid inhibiting activity (Panda et al. 2009). Nonadecene has cytotoxic activities; besides, it is good antifungal and anticancer agent (Arora and Kumar 2018).
In silico docking of two phytocompounds with the protein NF-ҡB had shown to follow the Lipinski’s rule of five. It is the rule which evaluates the drug likeliness of a subject compound, i.e., whether the experimental phytocompounds would fall under the criteria of a drug or not (Ogungbe et al. 2014). Here, menthone and proximadiol which we got in GC-MS analysis obeyed the all five criteria of Lipinski’s rule. Thus, the binding efficacy of menthone and proximadiol with NF-ҡβ protein supporting its uptake as anti-inflammatory agent.
The ROS plays a very important role in the generation of inflammatory conditions. Inflammation is a basic property of the cells elicited during its damage or poor health. Chronic inflammation can be seen in case of arthritis and even leads to cancer. The different antioxidant experiments reveal that the CML has potency to downregulate the quantity of ROS generated from different sources. In the in vivo system, carrageenan induces the activation of NF-κB which increases IL-8 cytokine production. This cytokine is a pro-inflammatory cytokine and helps in the upregulation of inflammation. In this well-known pathway, NF-κB plays the vital role and the same molecule was seen to interact with the active phytocompounds of CML in silico which further strengthens our assumption. We assumed a probable involvement of the CML phytocompounds with some of the prime inflammatory molecules that could hinder the progression of inflammation. In the other hand, many authors have described the role of synergy in the complementary medications where more than one compounds play vital role in disease amelioration and inhibits the disease more efficiently (Anilakumar et al. 2010). The in silico study provides a strong prediction of such interaction and establishes the usage of this herbal remedy as the subject of complementary medication.
Conclusion
Human cells have a tendency of generating ROS in day to day activities. Over production of ROS generally shifts cells oxidant-antioxidant pool. Besides, over production of these reactive oxygen species are involved in liver damage, kidney dysfunction, aging-related disorders, and inflammation. Juice of Citrus is known for ages as important health drink and several works have been done including the juices of C. macroptera. However, the activity of leaf extract of C. macroptera on human is largely elusive. In the present study, we have shown that CML extract is not only rich in antioxidant, but also is capable enough to cure selected ROS-related ailments particularly tissue inflammation. Our in vitro study was supported by in vivo evaluation on Wistar rat as well as by the in silico docking results. Therefore, it is evident from the present study that the leaf extract of C. macroptera could be a value addition in the list of health product related to Citrus. However, further study is required before its commercialization.
Availability of data and materials
All data including the results are provided within the article.
Abbreviations
- DPPH:
-
2,2-diphenyl-1-picrylhydrazyl
- ROS:
-
Reactive oxygen species
- CML:
-
Citrus macroptera leaf
- MIC:
-
Minimum inhibitory concentration
- NO:
-
Nitric oxide
- H2DCF:
-
2,7-dichlorofluorescein
- H2DCFDA:
-
2,7-dichlorodihydrofluorescein
References
Ahmed AU (2011) An overview of inflammation: mechanism and consequences. Front Biol 6(4):274
Akinyemi KO, Oladapo O, Okwara CE, Ibe CC (2005) Fasure KA Screening of crude extracts of six medicinal plants used in South-West Nigerian unorthodox medicine for anti-methicillin resistant Staphylococcus aureus activity. BMC Complement Altern Med 5:6
Anilakumar KR, Sudarshanakrishna KR, Chandramohan G, Ilaiyaraja N, Khanum F, Bawa AS (2010) Effect of Aloe vera gel extract on antioxidant enzymes and azoxymethane-induced oxidative stress in rats. Indian J Exp Biol 48(8):837–842
Anosike CA, Obidoa O (2012) Ezeanyika LUS Membrane stabilization as a mechanism of the anti-inflammatory activity of methanol extract of garden egg (Solanum aethiopicum). DARU J Pharma Sci 20:76
Arora S, Kumar G (2018) Phytochemical screening of root, stem and leaves of Cenchrus biflorus Roxb. J Pharmacognosy Phytochem 7:1445–1450
Aruoma OI (2003) Methodological considerations for characterizing potential antioxidant actions of bioactive components in plant foods. Mut Res Fundamental Mol Mechan Mutagenesis 523:9–20
Balaydin HT, Gulcin I, Menzek A, Goksu S, Sahin E (2010) Synthesis and antioxidant properties of diphenylmethane derivative bromophenols including a natural product. J Enzyme Inhibit Med Chem 25:685–695
Borthakur A, Bhattacharyya S, Anbazhagan AN, Kumar A, Dudeja PK, Tobacman JK (2012) Prolongation of carrageenan-induced inflammation in human colonic epithelial cells by activation of an NFKB-BCL 10 loop. Biochimica et Biophysica Acta (BBA)-Molecular Basis of Disease 1822:1300–1307
Bulkley GB (1983) The role of oxygen free radicals in human disease processes. Surgery 94:407–411
Bursal E, Koksal E, Gulcin I, Bilsel G, Goren AC (2013) Antioxidant activity and polyphenol content of cherry stem (Cerasus avium L.) determined by LC-MS/MS. Food Res Int 51:66–74
Cheung CK, Wyman JF, Halcon LL (2007) Use of complementary and alternative therapies in community-dwelling older adults. J Altern Complement Med 13:997–1006
Corley DA, Kerlikowske K, Verma R, Buffler P (2003) Protective association of aspirin/NSAIDs and esophageal cancer: a systematic review and meta-analysis. Gastroenterology 124:47–56
Dey P, Dutta S, Sarkar MP, Chaudhuri TK (2015) Assessment of hepatoprotective potential of N. indicum leaf on haloalkane xenobiotic induced hepatic injury in Swiss albino mice. Chem Biol Interact 235:37–46
Evans FE, Miller DW, Cairns T, Baddeley GV, Wenkert E (1982) Structure analysis of proximadiol (cryptomeridol) by 13C [carbon isotope] NMR spectroscopy [Cymbopogon proximus]. Phytochemistry 21:937–938
Gross C, Hen R (2004) The developmental origins of anxiety. Nat Rev Neurosci 5:545
Guan F, Yu J, Yu J, Liu Y, Li Y, Feng X, Huang KC, Chang Z, Ye S (2018) Lateral interactions between protofilaments of the bacterial tubulin homolog FtsZ are essential for cell division. eLife 7:e35578. https://doi.org/10.7554/eLife.35578
Gupta AK, Parasar D, Sagar A, Choudhary V, Chopra BS, Garg R, Khatri N (2015) Analgesic and anti-inflammatory properties of gelsolin in acetic acid induced writhing, tail immersion and carrageenan induced paw edema in mice. PLoS One 10:e0135558
Gupta M, Mazumder UK, Gomathi P, Selvan VT (2006) Antiinflammatory evaluation of leaves of Plumeria acuminata. BMC Complement Altern Med 6:36
Hanelt P Institute of plant genetics and crop plant research (Eds.)(2001): Mansfeld's Encyclopedia of Agricultural and Horticultural Crops. Springer, Berlin etc 1, no. 6 (2017): 3716.
Huang D, Ou B, Prior RL (2005) The chemistry behind antioxidant capacity assays. J Agric Food Chem 53:1841–1856
Misko TP, Radabaugh MR, Highkin M, Abrams M, Friese O, Gallavan R, Bramson C, Le Graverand MPH, Lohmander LS, Roman D (2013) Characterization of nitrotyrosine as a biomarker for arthritis and joint injury. Osteoarthr Cartil 21:151–156
Modak D, Paul S, Bhattacharjee S (2017) Anti-inflammatory activity of Acmella uliginosa (sw.) cass. flower methanolic extract on membrane stabilization and protein denaturation: an in-vitro evaluation. NBU J Anim Sc 11:61–69
Mustafa RA, Hamid AA, Mohamed S, Bakar FA (2010) Total phenolic compounds, flavonoids, and radical scavenging activity of 21 selected tropical plants. J Food Sci 75:C28–C35
Ogungbe IV, Erwin WR, Setzer WN (2014) Antileishmanial phytochemical phenolics: molecular docking to potential protein targets. J Mol Graph Model 48:105–117
Olurinola PF (1996) A laboratory manual of pharmaceutical microbiology: Nigeria: Idu. Abuja 69:1–105
Osadebe PO, Okoye FBC (2003) Anti-inflammatory effects of crude methanolic extract and fractions of Alchornea cordifolia leaves. J Ethnopharmacol 89:19–24
Panda S, Jafri M, Kar A, Meheta BK (2009) Thyroid inhibitory, antiperoxidative and hypoglycemic effects of stigmasterol isolated from Butea monosperma. Fitoterapia 80:123–126
Paul S, Hossen MS, Tanvir EM, Islam MA, Afroz R, Ahmmed I, Saha M, Gan SH, Khalil MI (2015) Antioxidant properties of citrus macroptera fruit and its in vivo effects on the liver, kidney and pancreas in wistar rats. Int J Pharmacol 11:899–909
Rahman H, Eswaraiah MC, Dutta A (2014) Neuropharmacological activities of ethanolic extract of Citrus macroptera (Varannamensis) fruit peels. Global J Pharmacol 8:609–616
Saha MR, Dey P, Begum S, De B, Chaudhuri TK, De Sarker D, Das AP, Sen A (2016) Effect of Acacia catechu (Lf) Willd. on oxidative stress with possible implications in alleviating selected cognitive disorders. PLoS One 11:e0150574
Sheir Z, Nasr AA, Massoud A, Salama O, Badra GA, El-Shennawy H, Hassan N, Hammad SM (2001) A safe, effective, herbal antischistosomal therapy derived from myrrh. Am J Trop Med Hygiene 65:700–704
Shinde UA, Phadke AS, Nair AM, Mungantiwar AA, Dikshit VJ, Saraf MN (1999) Membrane stabilizing activity -a possible mechanism of action for the anti-inflammatory activity of Cedrus deodara wood oil. Fitoterapia 70:251–257
Singleton VL, Rossi JA (1965) Colorimetry of total phenolics with phosphomolybdic-phosphotungstic acid reagents. Am J Enol Vitic 16:144–158
Stadtman ER (1992) Protein oxidation and aging. Science 257:1220–1224
Uddin N, Hasan MR, Hasan MM, Hossain MM, Alam MR, Hasan MR, Islam AFMM, Rahman T, Rana MS (2014) Assessment of toxic effects of the methanol extract of Citrus macroptera Montr. fruit via biochemical and hematological evaluation in female Sprague-Dawley rats. PLoS One 9:e111101
Wu D, Yotnda P (2011) Production and detection of reactive oxygen species (ROS) in cancers. J Vis Exp 57:e3357
Zhishen J, Mengcheng T, Jianming W (1999) The determination of flavonoid contents in mulberry and their scavenging effects on superoxide radicals. Food Chem 64:555–559
Funding
Not applicable.
Author information
Authors and Affiliations
Contributions
AS conceived the idea. AS, ML, SP, DM, AD, and SB designed the experiments. ML, DM, SP, and AD carried out the experiments. IS designed and analyzed the in silico portion. AK performs the ROS experiment. All the authors contributed in drafting the manuscript and approved it.
Corresponding author
Ethics declarations
Ethics approval
All the experiments using animals were monitored, reviewed, and approved by the Animal Ethical Committee of Department of Zoology, NBU (Permit No. 840/ac/04/CPCSEA, Committee for the Purpose of Control and Supervision of Experiments on Animals).
Competing interests
The authors declare that there are no competing interests.
Additional information
Publisher’s Note
Springer Nature remains neutral with regard to jurisdictional claims in published maps and institutional affiliations.
Rights and permissions
Open Access This article is licensed under a Creative Commons Attribution 4.0 International License, which permits use, sharing, adaptation, distribution and reproduction in any medium or format, as long as you give appropriate credit to the original author(s) and the source, provide a link to the Creative Commons licence, and indicate if changes were made. The images or other third party material in this article are included in the article's Creative Commons licence, unless indicated otherwise in a credit line to the material. If material is not included in the article's Creative Commons licence and your intended use is not permitted by statutory regulation or exceeds the permitted use, you will need to obtain permission directly from the copyright holder. To view a copy of this licence, visit http://creativecommons.org/licenses/by/4.0/.
About this article
Cite this article
Lala, M., Modak, D., Paul, S. et al. Potent bioactive methanolic extract of wild orange (Citrus macroptera Mont.) shows antioxidative, anti-inflammatory, and antimicrobial properties in in vitro, in vivo, and in silico studies. Bull Natl Res Cent 44, 81 (2020). https://doi.org/10.1186/s42269-020-00329-5
Received:
Accepted:
Published:
DOI: https://doi.org/10.1186/s42269-020-00329-5